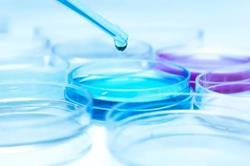

Chemical Solutions & Industrial Chemicals Supply
With over 40 years of experience, we provide industrial and specialty chemicals tailored to global markets.
Our products support water treatment, manufacturing, and industrial applications — backed by proprietary formulations and utility patents.
Our Expertise & Capabilities
Measuring
Samples Detection
Laboratory For Different Types Of Chemistry
Production
Automatic Solvent Extraction
Sample Inspection
Automatic Instrument
Automatic Filling
ICB Chemical Containers And Barrels
Industries & Applications
Case and Application Field
Provide professional solutions for all types of water problems

Water treatment
Used in urban sewage treatment/industrial wastewater treatment/potable water treatment.

Textile Industry
Used in textile wastewater treatment and textile production as thickening agent and textile sizing agent and so on.

Paper Mill
Used in urban sewage treatment/industrial wastewater treatment/potable water treatment.

Mining industry
Used in ore washing and flotation/mud settlement and clarification /solid-liquid separation of tailings and so on.

Oil & Gas industry
Used in water shutoff, drilling fluid, fracturing fluid, oil extraction, fluid loss reduction, flocculation, shale inhibition, dilution, plugging, cooling and lubrication of drill bits and drill strings, campingcuttings, cementing and so on during Dilling process.
Other Fields
Used in sugar industry/breeding/ agriculture/pharmaceutical/ architecture/constructionand others.
Application
Energy Generation Processes in Wastewater Treatment Plants
The sludge produced in the primary and secondary sedimentation basins is heated in a digestion tower to a temperature of between 35 °C and 40 °C. This airtight process, which lasts for up to 25 days, causes the sludge to decompose. Anaerobic bacteria break down the sludge into fermentation gas, water, and sapropel. The gas mixture created consists of around 70 % methane and 30 % carbon dioxide. In the gas cleaning plant, methane is extracted from hydrogen sulphide through a chemical reaction between the gas and cleaning solution. The gas is either burned off or temporarily placed in a storage tank for energy generation before being transported to a power plant or fed into a public gas grid.
Goal
Optimise anaerobic decomposition and safety
To optimize the anaerobic decomposition of sludge in the digestion tower, it is essential that temperature and pressure are monitored reliably. In addition, the formation and removal of foam by an agitator is monitored. This prevents the plant from being flooded with foam and stops pipe blockages while also increasing the gas yield. The quality of the gas produced is analysed so that any fluctuations in the heating value can be detected. This data indicates possible overheating in the pumps and may be used to regulate the combined heat and power plant located downstream. The pressure and fill level in the gas storage tank is monitored to prevent any overload in the tank and conduits and to stop gas from escaping.
Energy Generation Processes in Wastewater Treatment Plants
Solution
K-System interface components for hazardous areas
The K-System portfolio offers interface components for all signal types and applications. Since digestion towers and their secondary systems are essentially explosion-hazardous areas, K-System isolated barriers can be used as interface modules. Transmitter power supplies report the level and pressure measurements in the digestion tower to the control panel while temperature converters report analogue temperature values. Frequency converters in conjunction with discrete sensors record and transfer motor data. Gas analysers transfer their results to the control panel via signal converters. The fill level and pressure measurements in the gas storage tank are transmitted in the same manner.
Benefits
Why choose the K-System portfolio
The K-System portfolio offers interface components for all signal types and applications—ranging from common signal conditioner to highly functional Ex components. The Power Rail powers the devices and provides a collective error message. It consists of a DIN rail with an insert component. The DIN rail mounting reduces wiring costs by making it easy to plug in the modules. In addition, the K-System has many international approvals up to SIL 3 for all signal types.
At a Glance
The wastewater treatment plant generates energy from sludge in the digestion tower. A by-product of the digestion tower, fermentation gas is stored and used in various ways.
Analog values such as the pressure and temperature in the digestion tower and in the gas storage tank, as well as the gas analysis data, are transmitted to the control panel by signal converters or transmitter power supplies. Frequency converters monitor the rotational speed of the agitators that remove foam.
Five Types of Chemicals Used in Wastewater Treatment
1. Aluminium Sulphate
Aluminium sulphate is used in wastewater plants and acts as a purifier of the wastewater. The chemical itself is soluble and reacts to the chemicals in wastewater easily.
2. Sodium Aluminate
Sodium aluminate is an inorganic compound. The liquid form works well as a phosphorus remover. Wastewater usually contains phosphorus, which can create hard deposits.
3. Polymer
Polymer is a commonly used chemical that has many functions in industry, especially for plastic manufacturing industries. Polymer is also beneficial in wastewater treatment plants.
4. Sodium Hydroxide
Another chemical that functions as a substance used in wastewater treatment plants is sodium hydroxide. Sodium hydroxide belongs to an inorganic compound with the symbol NaOH.
5. Hydrochloric Acid
- While some chemicals work to elevate ph level, there are also chemicals to lower the ph levels. One of them is hydrochloric acid
- While the chemical has many uses in industry, it is also used in wastewater treatment.
- Hydrochloric acid’s primary function is to lower the ph of the wastewater.
Wastewater Treatment Plants
Advanced Water & Wastewater Treatment Plant
Introduction: Water is the most important natural gift for human being and aquatic life. Due to continuous technological growth and industrialization, the water has been fully polluted and categorized as water pollution. The outlet water of industries and human which accedes the limit of organic and inorganic components in the water is called wastewater (polluted water).
Sources of Wastewater:
- Industrial
- Municipal
- Commercial
Characteristics of Wastewater:
- Physical Characteristics
- Chemical Characteristics
- Biological Characteristics
Impurities in Wastewater:
- Suspended Impurities
- Dissolved Impurities
- Colloidal Impurities
Some of them appear in dissolved form, some of suspended form and some of colloidal form. To maintain the quality of water, its need the treatment of wastewater. The basic treatments of wastewater are:
- Preliminary Treatment
- Primary Treatment
- Secondary treatment
- Advanced treatment
Advanced Treatment:
Advanced Treatment of Wastewater Plant is defined as the additional treatment needed to remove suspended, colloidal, and dissolved impurities remaining after conventional secondary treatment Dissolved constituents may range from relatively simple inorganic components, such as sand, clay, calcium, potassium, sulphate, nitrate, and phosphate. There are many technologies adapting in advanced treatment like- Media filtration, Membrane filtration (RO, VSEP, MBR, Micro filtration, Ultra filtration, Nano filtration), Ion exchange, DM, OS, Distillation, MEE, CAACO, Carbon adsorption, Advanced oxidation, etc. The typical flow diagrams of advanced treatments as follows:
SEVERAL PROBLEMS ARE OVERCOME WITH CAACO SYSTEM
Wastewater enters the top of a reactor vessel packed with media, where it is aerated by an air-lift venturi or diffuser system. Once acclimated, the microbes are highly resistant to shock caused by shock changes in COD/BOD loading or exposure to toxins. Operating costs for CAACO SYSTEM are low. The system provides very efficient oxygen transfer to the water, minimizing the airflow required. The inherent simplicity of the design minimizes maintenance requirements. Sludge is not generated: eliminating requirement for secondary clarification.CAACO SYSTEM can be adapted for use with specially developed microbial populations, including for nitrogen and phosphorous removal.
SOME ADVANCED TREATMENT AND THEIR COMPRISION
Now days the advanced water and wastewater treatment process are adapting mostly for recycle, reuse, maintain zero discharge, irrigation, municipal (seaways treatment), all processing industries (Textiles, Oil Refineries, Petrochemicals, Pharmaceuticals, Food and Beverages, Ternaries, Dairies, Distilleries, Thermal, and other chemical processing industries), we have given some examples of advanced Treatment.
The best technology to preserve your water resources
We collaborate with our associates as subcontractor; they are leading specialists in water treatment. The teams design and deliver drinking water or wastewater treatment plants as well as smaller standardized water treatment equipment for industrial or municipal customers. They also offer a range of services (audit, maintenance, digital, etc.) to cover all water treatment plant management needs.
Solutions for a sustainable world –We create technologies for sustainable development. Our expertise is deliberately focused on preserving the environment: we help you reduce your carbon footprint and optimize your water consumption, in particular through our (ZLD) offer, which aims to reuse wastewater after treatment within the plant. We also offer you methanization solutions to exploit the energy produced from your plant’s water treatment. The biogas generated in this way can be consumed within the plant, in a nearby plant or in the municipality’s distribution network. We provided this for Artois Methanisation with our colleagues. Our objective is to help you preserve water and energy resources.
Our expertise at your service
Our associate’sglobal presence and their 160 years of experience are unique in the world and allow them to base their technologies on years of practice and innovation to best serve the customers. We are constantly evolving to meet your needs, whether in after-sales services or product innovation.
Being competitive while preserving water resources is possible
Our solutions are designed to make you more competitive: reducing your operating costs, strengthening your company’s social responsibility and ensuring the efficient management of your installations. To meet your needs as quickly as possible, we have also developed a range of standardized products and are constantly working on the development of new offers to adapt to changing needs and long-term development.